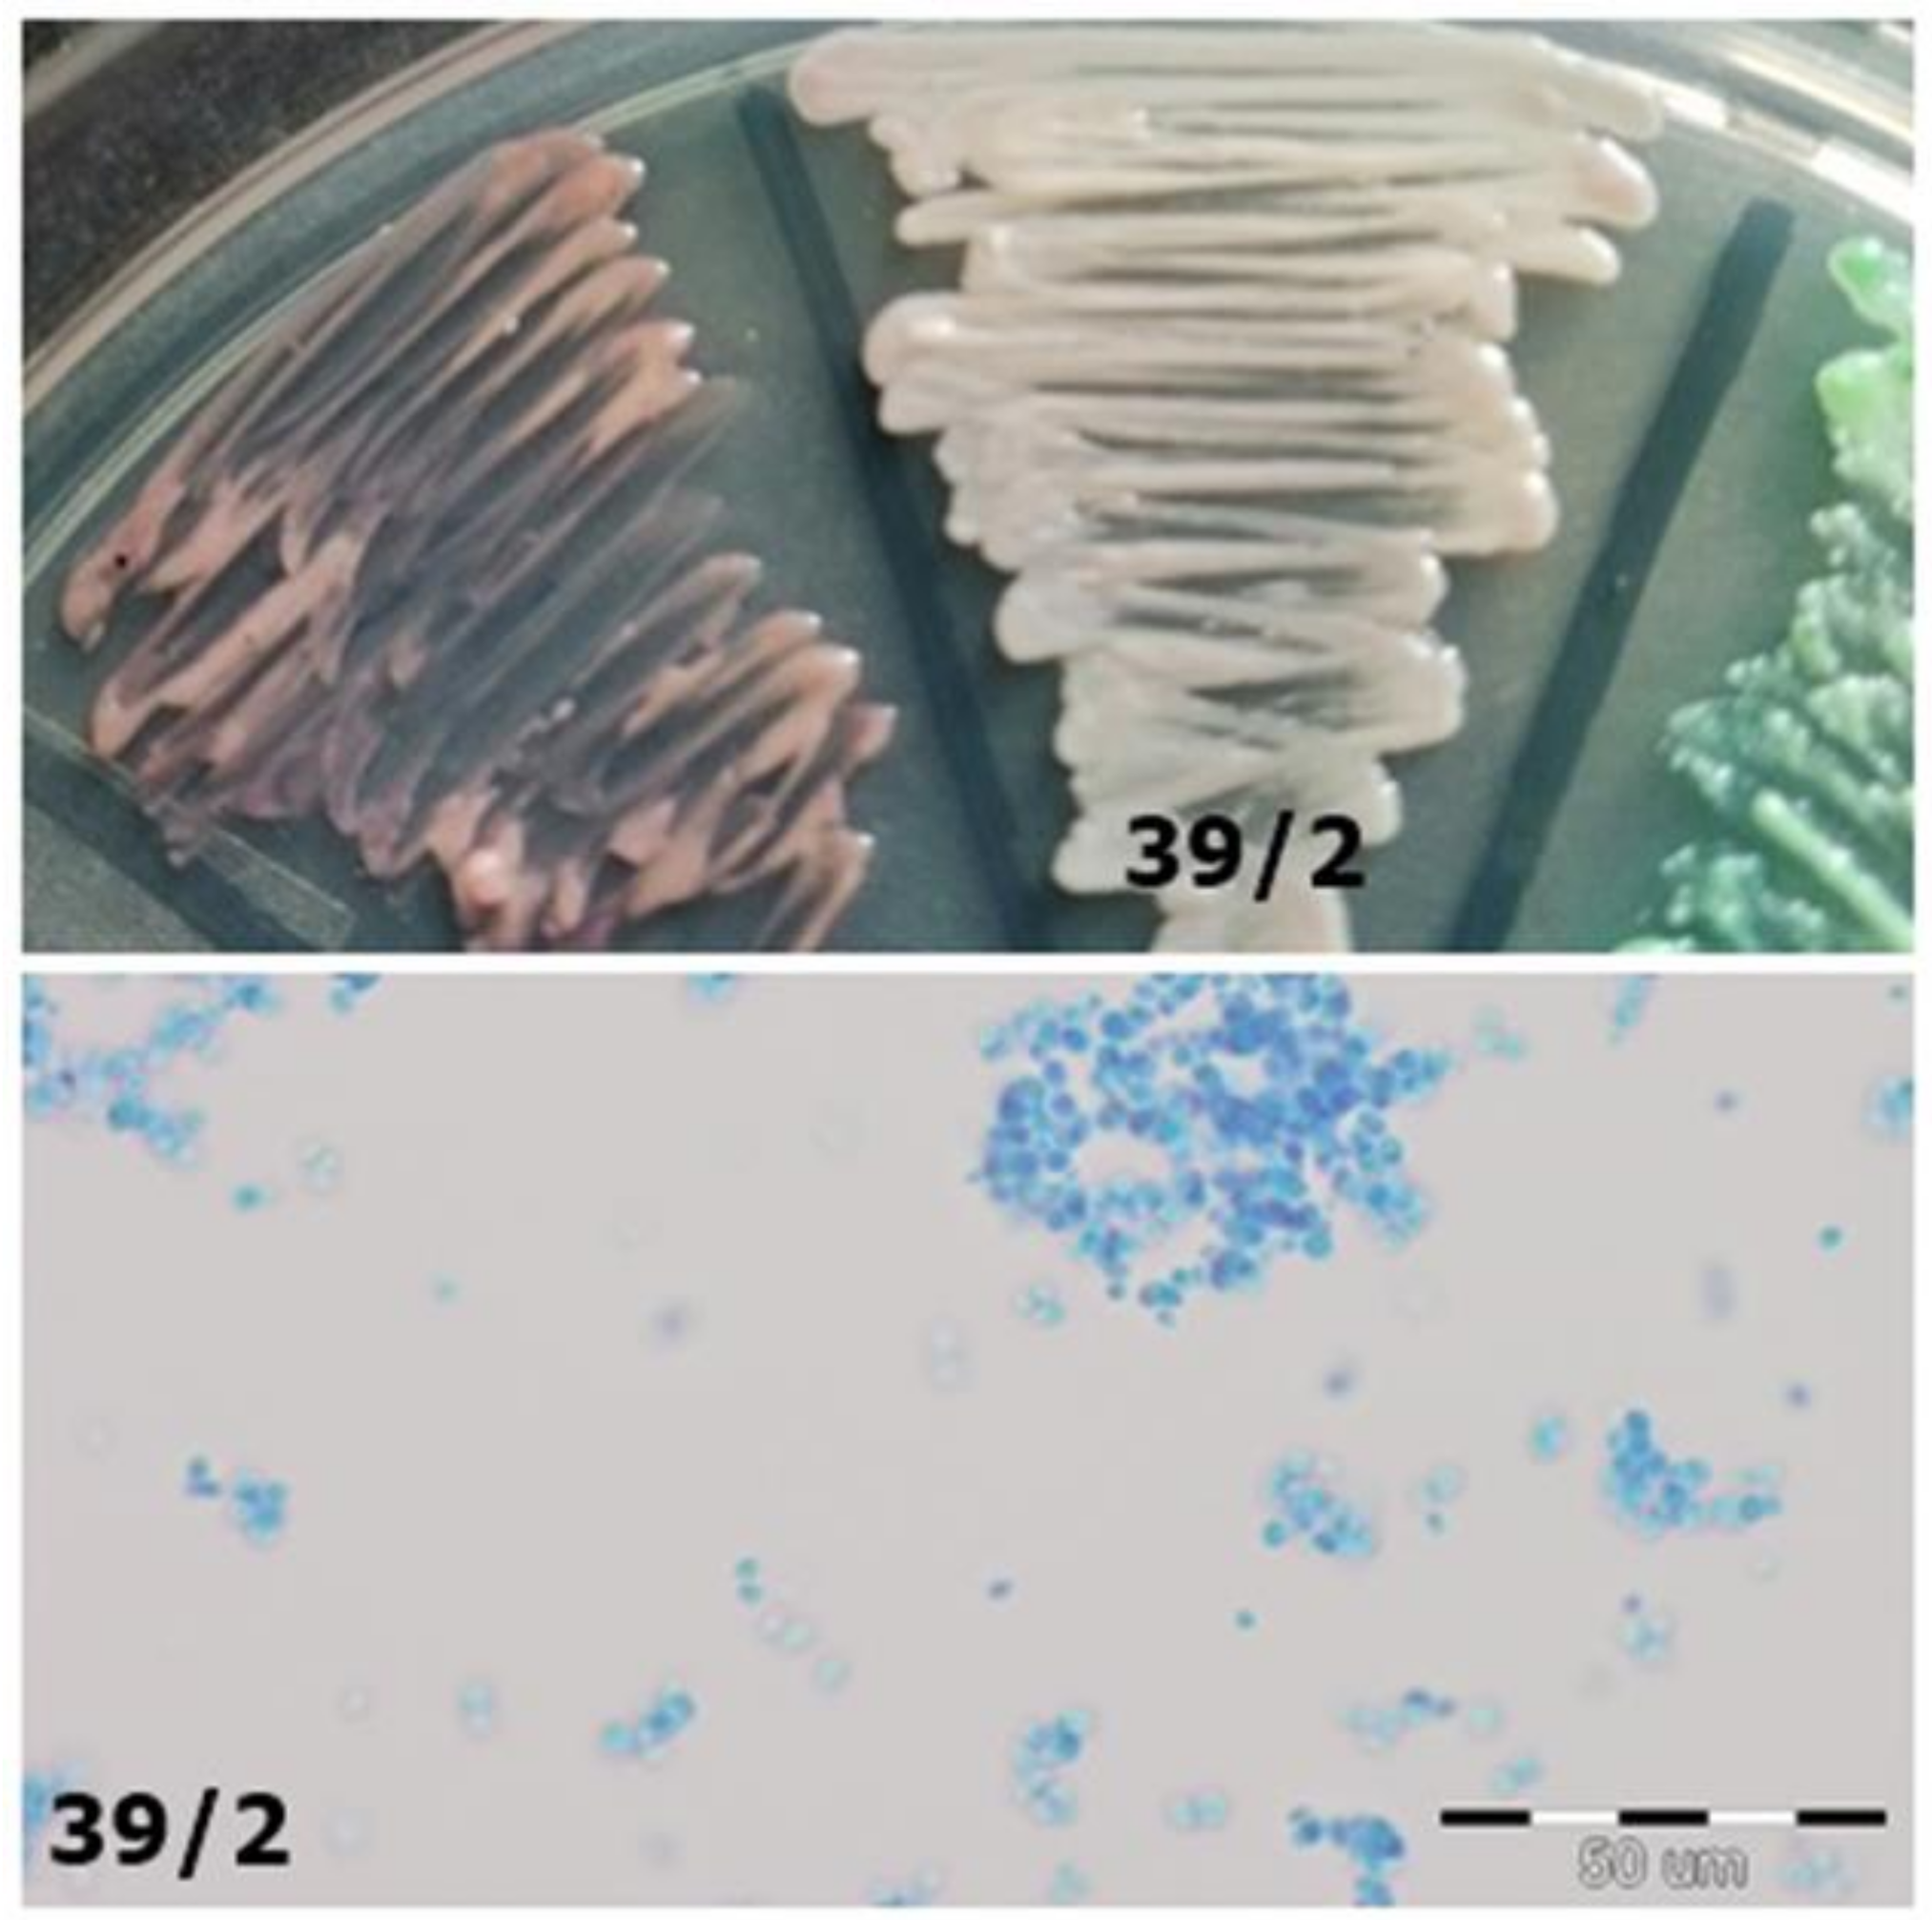
Jcm 10 01570 g005

Identification of Fungi Isolated from Oral Cavity of Patients with HIV Using MALDI–TOF MS
Abstract
1. Introduction
- assess the colony macroscopically—Sabouraud medium; potato or corn medium.
- assess the fungi (mycelium, hyphae, chlamydospores) microscopically—rice medium; corn medium.
- assess the biochemical features of the fungi—commercial chromogenic media (ChromAgar Candida Becton Dickinson, Chromogenic Candida Selective Agar ARGENTA).
2. Materials and Methods
3. Results
- In the study group (patients with HIV), positive fungal cultures were detected 66 times (95% of the sample), whereas in the control group (healthy people), only 14 times (48% of the sample).
- All 80 strains (100% of positive cultures) were tested with classical microbiological methods and with MALDI–TOF MS.
- Altogether, consistency of yeast-like fungi identification isolated from oral cavity swabs between classical microbiological methods and MALDI–TOF MS was obtained in 45 cases (~56%). The analyzed methods presented different results in 35 cases (~44%).
- Identification in the study group was compatible in half of the strains (33 strains) and incompatible in another half of the strains (33 strains) (Table 1).
- The consistency of identification between strains isolated from healthy individuals (control group) was greater. Twelve strains were identified to the same species with the classical method and MALDI–TOF, whereas only 2 strains were identified differently (Table 2).
- Ten strains from the study group were identified only to the genus level using classical methods. Six of them were identified as C. tropicalis, one as C. dubliniensis, one as C. inconspicua, and one as C. parapsilosis by MALDI–TOF MS. One strain was identified as Pseudomonas aeruginosa using MALDI–TOF MS.
- Among the 25 other cases, the results were different using classical methods and MALDI–TOF MS when it came to species identification. Twenty-three of them came from the study group and two from the control group. The most common difference was the identification of the strains as C. albicans using the classical methods and as C. dubliniensis using MALDI–TOF MS. This situation occurred in 20 cases: 19 from the study group and 1 from the control group. In one case, the situation was the opposite: in the control group, one strain was identified as C. dubliniensis by classical methods, whereas MALDI–TOF MS detected C. albicans.
- MALDI–TOF MS detected two strains as bacteria: the abovementioned Pseudomonas aeruginosa and Rothia mucilaginosa. In one case, MALDI–TOF MS was not able to perform the identification (Table 3).
- Colonisation by two different species of Candida fungi was detected in three patients using classical methods. However, during MALDI-TOF MS analysis, it turned out that the isolated fungi were of the same species, so the patients were colonized only by a single species.
- From 11 Sabouraud media plates that did not show any sign of fungal growth, three turned out to show some colony growth after multiplying the material in Sabouraud broth, a liquid medium. All of them came from the control group.
4. Discussion
5. Conclusions
Author Contributions
Funding
Institutional Review Board Statement
Informed Consent Statement
Data Availability Statement
Acknowledgments
Conflicts of Interest
References
- Neppelenbroek, K.H.; Seó, R.S.; Urban, V.M.; Silva, S.; Dovigo, L.N.; Jorge, J.H.; Campanha, N.H. Identification of Candida species in the clinical laboratory: A review of conventional, commercial, and molecular techniques. Oral Dis. 2014, 20, 329–344. [Google Scholar] [CrossRef] [PubMed]
- Maldonado, I.; Cataldi, S.; Garbasz, C.; Relloso, S.; Striebeck, P.; Guelfand, L.; López Moral, L. Identification of Candida yeasts: Conventional methods and MALDI-TOF MS. Rev. Iberoam. Micol. 2018, 35, 151–154. [Google Scholar] [CrossRef] [PubMed]
- Almeida-Silva, F.; Damasceno, L.S.; Serna, M.J.; Valero, C.; Quintella, L.P.; Almeida-Paes, R.; Muniz Mde, M.; Zancope-Oliveira, R.M. Multiple opportunistic fungal infections in an individual with severe HIV disease: A case report. Rev. Iberoam. Micol. 2016, 33, 118–121. [Google Scholar] [CrossRef] [PubMed]
- Vargas, K.; Messer, S.A.; Pfaller, M.; Lockhart, S.R.; Stapleton, J.T.; Hellstein, J.; Soll, D.R. Elevated Phenotypic Switching and Drug Resistance of Candida albicans from Human Immunodeficiency Virus-Positive Individuals prior to First Thrush Episode. J. Clin. Microbiol. 2000, 38, 3595–3607. [Google Scholar] [CrossRef]
- Dingle, T.C.; Butler-Wu, S.M. Maldi-tof mass spectrometry for microorganism identification. Clin. Lab. Med. 2013, 33, 589–609. [Google Scholar] [CrossRef]
- Ibáñez-Martínez, E.; Ruiz-Gaitán, A.; Pemán-García, J. Update on the diagnosis of invasive fungal infection. Rev. Esp. Quimioter. 2017, 30 (Suppl. 1), 16–21. [Google Scholar]
- Krzyściak, P.; Skóra, M.; Macura, A.B. Atlas Grzybów Chorobotwórczych Człowieka; MedPharm Polska: Wrocław, Poland, 2010. [Google Scholar]
- Nawrot, U.; Włodarczyk, K.; Skała, J.; Przondo-Mordarska, A.; Nolard, N. Ocena przydatności chromogennego podłoża CandiSelect 4(BioRad) do izolacji i wstępnej identyfikacji grzybów z rodzaju Candida. Mikol. Lek. 2005, 12, 267–272. [Google Scholar]
- Kawalec, A.; Białecka, A.; Kasprowicz, A.; Barabasz, W. Identyfikacja grzybów drożdżopodobnych izolowanych z dróg rodnych kobiet z wykorzystaniem spektrometrii mas typu MALDI-TOF. Med. Dośw. Mikrobiol. 2016, 68, 127–134. [Google Scholar]
- Hou, T.Y.; Chiang-Ni, C.; Teng, S.H. Current status of MALDI-TOF mass spectrometry in clinical microbiology. J. Food Drug Anal. 2019, 27, 404–414. [Google Scholar] [CrossRef]
- Singhal, N.; Kumar, M.; Kanaujia, P.K.; Virdi, J.S. MALDI-TOF mass spectrometry: An emerging technology for microbial identification and diagnosis. Front. Microbiol. 2015, 6, 791. [Google Scholar] [CrossRef]
- Croxatto, A.; Prod’hom, G.; Greub, G. Applications of MALDI-TOF mass spectrometry in clinical diagnostic microbiology. FEMS Microbiol. Rev. 2012, 36, 380–407. [Google Scholar] [CrossRef]
- Rodríguez-Sánchez, B.; Cercenado, E.; Coste, A.T.; Greub, G. Review of the impact of MALDI-TOF MS in public health and hospital hygiene, 2018. Euro Surveill. 2019, 24, 1800193. [Google Scholar] [CrossRef]
- Deepak, S.; Kottapalli, K.; Rakwal, R.; Oros, G.; Rangappa, K.; Iwahashi, H.; Masuo, Y.; Agrawal, G. Real-Time PCR: Revolutionizing Detection and Expression Analysis of Genes. Curr. Genomics 2007, 8, 234–251. [Google Scholar] [CrossRef]
- Oviaño, M.; Rodríguez-Sánchez, B. MALDI-TOF mass spectrometry in the 21st century clinical microbiology laboratory. Enferm. Infecc. Microbiol. Clin. 2020, 39, 192–200. [Google Scholar] [CrossRef]
- Sow, D.; Fall, B.; Ndiaye, M.; Ba, B.S.; Sylla, K.; Tine, R.; Lô, A.C.; Abiola, A.; Wade, B.; Dieng, T.; et al. Usefulness of MALDI-TOF Mass Spectrometry for Routine Identification of Candida Species in a Resource-Poor Setting. Mycopathologia 2015, 180, 173–179. [Google Scholar] [CrossRef]
- Carbonelle, E.; Mesquita, C.; Bille, E.; Day, N.; Dauphin, B.; Beretti, J.L.; Ferroni, A.; Gutmann, L.; Nassif, X. MALDI-TOF mass spectrometry tools for bacterial identification in clinical microbiology laboratory. Clin. Biochem. 2011, 44, 104–109. [Google Scholar] [CrossRef]
- Chao, Q.T.; Lee, T.F.; Teng, S.H.; Peng, L.Y.; Chen, P.H.; Teng, L.J.; Hsueh, P.R. Comparison of the accuracy of two conventional phenotypic methods and two MALDI-TOF MS systems with that of DNA sequencing analysis for correctly identifying clinically encountered yeasts. PLoS ONE 2014, 9, e109376. [Google Scholar] [CrossRef]
- Zhao, Y.; Tsang, C.C.; Xiao, M.; Chan, J.F.W.; Lau, S.K.P.; Kong, F.; Xu, Y.; Woo, P.C.Y. Yeast identification by sequencing, biochemical kits, MALDI-TOF MS and rep-PCR DNA fingerprinting. Med. Mycol. 2018, 56, 816–827. [Google Scholar] [CrossRef]
- Posteraro, B.; Vella, A.; Cogliati, M.; De Carolis, E.; Florio, A.R.; Posteraro, P.; Sanguinetti, M.; Tortorano, A.M. Matrix-assisted laser desorption ionization-time of flight mass spectrometry-based method for discrimination between molecular types of Cryptococcus neoformans and Cryptococcus gattii. J. Clin. Microbiol. 2012, 50, 2472–2476. [Google Scholar] [CrossRef]
- Kolecka, A.; Khayhan, K.; Groenewald, M.; Theelen, B.; Arabatzis, M.; Velegraki, A.; Kostrzewa, M.; Mares, M.; Taj-Aldeen, S.J.; Boekhout, T. Identification of medically relevant species of arthroconidial yeasts by use of matrix-assisted laser desorption ionization-time of flight mass spectrometry. J. Clin. Microbiol. 2013, 51, 2491–2500. [Google Scholar] [CrossRef]
- Denis, J.; Machouart, M.; Morio, F.; Sabou, M.; Kauffmann-LaCroix, C.; Contet-Audonneau, N.; Candolfi, E.; Letscher-Bru, V. Performance of Matrix-Assisted Laser Desorption Ionization-Time of Flight Mass Spectrometry for Identifying Clinical Malassezia Isolates. J. Clin. Microbiol. 2016, 55, 90–96. [Google Scholar] [CrossRef] [PubMed]
- Rath, S.; Das, S.R.; Padhy, R.N. Bayesian analysis of two methods MALDI-TOF-MS system and culture test in otomycosis infection. World J. Otorhinolaryngol. Head Neck Surg. 2019, 5, 6–13. [Google Scholar] [CrossRef] [PubMed]
- Pulcrano, G.; Iula, D.V.; Vollaro, A.; Tucci, A.; Cerullo, M.; Esposito, M.; Rossano, F.; Catania, M.R. Rapid and reliable MALDI-TOF mass spectrometry identification of Candida non-albicans isolates from bloodstream infections. J. Microbiol. Methods 2013, 94, 262–266. [Google Scholar] [CrossRef] [PubMed]
- Gutiérrez, J.; Morales, P.; González, M.A.; Quindós, G. Candida dubliniensis, a new fungal pathogen. J. Basic Microbiol. 2002, 42, 207–227. [Google Scholar] [CrossRef]
- Momani, O.M.; Qaddoomi, A. Identification of Candida dubliniensis in a diagnostic microbiology laboratory. East Mediterr. Health J. 2005, 11, 366–371. [Google Scholar] [PubMed]
- Paugam, A.; Baixench, M.T.; Viguié, C. Actualités sur Candida dubliniensis [An update on Candida dubliniensis]. Med. Mal. Infect. 2008, 38, 1–7. [Google Scholar] [CrossRef]
- Asadzadeh, M.; Ahmad, S.; Al-Sweih, N.; Khan, Z. Rapid and Accurate Identification of Candida albicans and Candida dubliniensis by Real-Time PCR and Melting Curve Analysis. Med. Princ. Pract. 2018, 27, 543–548. [Google Scholar] [CrossRef]
- Tintelnot, K.; Haase, G.; Seibold, M.; Bergmann, F.; Staemmler, M.; Franz, T.; Naumann, D. Evaluation of phenotypic markers for selection and identification of Candida dubliniensis. J. Clin. Microbiol. 2000, 38, 1599–1608. [Google Scholar] [CrossRef]
- Mesa, L.M.; Arcaya, N.; Cañas, O.; Machado, Y.; Calvo, B. Evaluación de los caracteres fenotípicos para diferenciar Candida Albicans de Candida dubliniensis [Phenotypic evaluation to differentiate Candida albicans from Candida dubliniensis]. Rev. Iberoam. Micol. 2004, 21, 135–138. [Google Scholar]
- Odds, F.C.; Davidson, A. “Room temperature” use of CHROMagar Candida. Diagn. Microbiol. Infect. Dis. 2000, 38, 147–150. [Google Scholar] [CrossRef]
- Hof, H.; Eigner, U.; Maier, T.; Staib, P. Differentiation of Candida dubliniensis from Candida albicans by means of MALDI-TOF mass spectrometry. Clin. Lab. 2012, 58, 927–931. [Google Scholar] [CrossRef]
- de Barros, P.P.; Rossoni, R.D.; Freire, F.; Ribeiro, F.C.; Lopes, L.A.D.C.; Junqueira, J.C.; Jorge, A.O.C. Candida tropicalis affects the virulence profile of Candida albicans: An in vitro and in vivo study. Pathog. Dis. 2018, 76, 1–9. [Google Scholar] [CrossRef]
- Negri, M.; Silva, S.; Breda, D.; Henriques, M.; Azeredo, J.; Oliveira, R. Candida tropicalis biofilms: Effect on urinary epithelial cells. Microb. Pathog. 2012, 53, 95–99. [Google Scholar] [CrossRef]
- Silva, S.; Negri, M.; Henriques, M.; Oliveira, R.; Williams, D.W.; Azeredo, J. Candida glabrata, Candida parapsilosis and Candida tropicalis: Biology, epidemiology, pathogenicity and antifungal resistance. FEMS Microbiol. Rev. 2012, 36, 288–305. [Google Scholar] [CrossRef]
- Xisto, M.I.; Caramalho, R.D.; Rocha, D.A.; Ferreira-Pereira, A.; Sartori, B.; Barreto-Bergter, E.; Junqueira, M.L.; Lass-Flörl, C.; Lackner, M. Pan-azole-resistant Candida tropicalis carrying homozygous erg11 mutations at position K143R: A new emerging superbug? J. Antimicrob. Chemother. 2017, 72, 988–992. [Google Scholar]
- Arastehfar, A.; Daneshnia, F.; Hafez, A.; Khodavaisy, S.; Najafzadeh, M.J.; Charsizadeh, A.; Zarrinfar, H.; Salehi, M.; Shahrabadi, Z.Z.; Sasani, E.; et al. Antifungal susceptibility, genotyping, resistance mechanism, and clinical profile of Candida tropicalis blood isolates. Med. Mycol. 2020, 58, 766–773. [Google Scholar] [CrossRef]
- Lomeli-Martinez, S.M.; Valentin-Goméz, E.; Varela-Hernández, J.J.; Alvarez-Zavala, M.; Sanchez-Reyes, K.; Ramos-Solano, M.; Cabrera-Silva, R.I.; Ramirez-Anguiano, V.M.; Lomeli-Martinez, M.A.; Martinez-Salazar, S.Y.; et al. Candida spp. Determination and Th1/Th2 Mixed Cytokine Profile in Oral Samples From HIV+ Patients With Chronic Periodontitis. Front. Immunol. 2019, 10, 1465. [Google Scholar] [CrossRef]
- Paul, S.; Kannan, I. Molecular identification and antifungal susceptibility pattern of Candida species isolated from HIV infected Patients with candisiasis. Curr. Med. Mycol. 2019, 5, 21–26. [Google Scholar] [CrossRef]
- Delavy, M.; Cerutti, L.; Croxatto, A.; Prod’hom, G.; Sanglard, D.; Greub, G.; Coste, A.T. Machine Learning Approach for Candida albicansFluconazole Resistance Detection Using Matrix-Assisted Laser Desorption/Ionization Time-of-Flight Mass Spectrometry. Front. Microbiol. 2020, 10, 3000. [Google Scholar] [CrossRef]
- Brackmann, M.; Leib, S.L.; Tonolla, M.; Schürch, N.; Wittwer, M. Antimicrobial resistance classification using MALDI-TOF-MS is not that easy: Lessons from vancomycin-resistant Enterococcus faecium. Clin. Microbiol. Infect. 2020, 26, 391–393. [Google Scholar] [CrossRef]
- UNC Finds Cost Of MALDI-TOF System Is Offset In 3 Years. Available online: https://www.rapidmicrobiology.com/news/maldi-tof-identification-system-cost-offset-3-years (accessed on 27 May 2014).
- Maheshwari, M.; Kaur, R.; Chadha, S. Candida Species Prevalence Profile in HIV Seropositive Patients from a Major Tertiary Care Hospital in New Delhi, India. J. Pathog. 2016, 2016, 6204804. [Google Scholar] [CrossRef] [PubMed]
- Paul, S.; Singh, P.; Rudramurthy, S.M.; Chakrabarti, A.; Ghosh, A.K. Rapid detection of fluconazole resistance in Candida tropicalis by MALDI-TOF MS. Med. Mycol. 2018, 56, 234–241. [Google Scholar] [CrossRef] [PubMed]

| Study Group/Patients with HIV | Number of Strains | Classical Methods | MALDI–TOF MS | |
|---|---|---|---|---|
| Total | Single | |||
| Consistent results | 33 | 20 | C. albicans | C. albicans |
| 5 | C. dubliniensis | C. dubliniensis | ||
| 6 | C. glabrata | C. glabrata | ||
| 1 | C. krusei | C. krusei | ||
| 1 | C. tropicalis | C. tropicalis | ||
| Inconsistent results | 33 | 19 | C. albicans | C. dubliniensis |
| 1 | C. albicans | C. tropicalis | ||
| 1 | C. glabrata | Cryptococcus laurenti | ||
| 1 | C. glabrata | C. albicans | ||
| 6 | Candida spp. | C. tropicalis | ||
| 1 | Candida spp. | C. dubliniensis | ||
| 1 | Candida spp. | C. inconspicua | ||
| 1 | Candida spp. | C. parapsilosis | ||
| 1 | Candida spp. | Pseudomonas fluorescens | ||
| 1 | Rhodothorula | Rothia mucilaginosa | ||
| Control Group/Healthy Individuals | Number of Strains | Classical Methods | MALDI–TOF MS | |
|---|---|---|---|---|
| Total | Single | |||
| Consistent results | 12 | 5 | C. albicans | C. albicans |
| 6 | C. dubliniensis | C. dubliniensis | ||
| 1 | C. glabrata | C. glabrata | ||
| Inconsistent results | 2 | 1 | C. albicans | C. dubliniensis |
| 1 | C. dubliniensis | C. albicans | ||
| Strain No. | Classical Method—Plate Method CHromAgar/Sabouraud Agar | MALDI–TOF MS | Comments |
|---|---|---|---|
| HIV-positive patients | |||
| 1 | C. glabrata | Cryptococcus laurentii | Violet on the CHROMagar substrate/plate In the preparation with Lactophenol, the cells are round, ovate (Figure 1) |
| 4 | Rhodotorula spp. | Rothia mucilaginosa | Coral color on Sabouraud Agar; In the preparation with Lactophenol, round, ellipsoidal cells with a size of 3.5–6.5 µm, proving that they are fungal cells (Figure 2) |
| 5/1 | Candida sp. | Candida dubliniensis | Creamy matte on a Sabouraud Agar; on ChROMagar, green (lighter than in 5/2 strain) (Figure 3) |
| 5/2 | C. albicans | Candida dubliniensis | Shiny white on Sabouraud Agar; on CHROMagar, green medium (darker than in the 5/1 strain) (Figure 3) |
| 52/1 | C. glabrata | Problems with identification | Violet on ChromAgar In the preparation with Lactophenol, cells similar to Candida glabrata (Figure 4) |
| 39/2 | C. glabrata | C. albicans | Iridescent with purple edges, like C. glabrata; it is not green, as is the case with C. albicans (Figure 5) |
| 57/1 | Candida spp. | C. tropicalis | No clear color on the CHROMagar; there is also no sea color, dark blue, or gray-blue to indicate the presence of Candida tropicalis on CHROMagar (Figure 6) |
| 57/2 | C. albicans | C. dubliniensis | Green on CHROMagar (Figure 6) |
| 56/1 | Candida spp. | C. incospicua | Shiny white on CHROMagar (Figure 6) |
| 19/1 | Candida spp. | C. parapsilosis | White on CHROMagar (Figure 6) |
| 25/2 | Problems with identification | Pseudomonas fluorescens | Poor/inhibition growth on CHROMagar; opalescent on Sabouraud agar (Figure 7) |
| Healthy patients | |||
| 7K/1 | Candida albicans | Candida albicans | Light green on CHROMagar; Shiny white on Sabouraud agar (Figure 8) |
Publisher’s Note: MDPI stays neutral with regard to jurisdictional claims in published maps and institutional affiliations. |
© 2021 by the authors. Licensee MDPI, Basel, Switzerland. This article is an open access article distributed under the terms and conditions of the Creative Commons Attribution (CC BY) license (https://creativecommons.org/licenses/by/4.0/).
Share and Cite
Pawlak, Z.; Andrusiów, S.; Pajączkowska, M.; Janczura, A. Identification of Fungi Isolated from Oral Cavity of Patients with HIV Using MALDI–TOF MS. J. Clin. Med. 2021, 10, 1570. https://doi.org/10.3390/jcm10081570
Pawlak Z, Andrusiów S, Pajączkowska M, Janczura A. Identification of Fungi Isolated from Oral Cavity of Patients with HIV Using MALDI–TOF MS. Journal of Clinical Medicine. 2021; 10(8):1570. https://doi.org/10.3390/jcm10081570
Chicago/Turabian StylePawlak, Zuzanna, Szymon Andrusiów, Magdalena Pajączkowska, and Adriana Janczura. 2021. "Identification of Fungi Isolated from Oral Cavity of Patients with HIV Using MALDI–TOF MS" Journal of Clinical Medicine 10, no. 8: 1570. https://doi.org/10.3390/jcm10081570
APA StylePawlak, Z., Andrusiów, S., Pajączkowska, M., & Janczura, A. (2021). Identification of Fungi Isolated from Oral Cavity of Patients with HIV Using MALDI–TOF MS. Journal of Clinical Medicine, 10(8), 1570. https://doi.org/10.3390/jcm10081570

